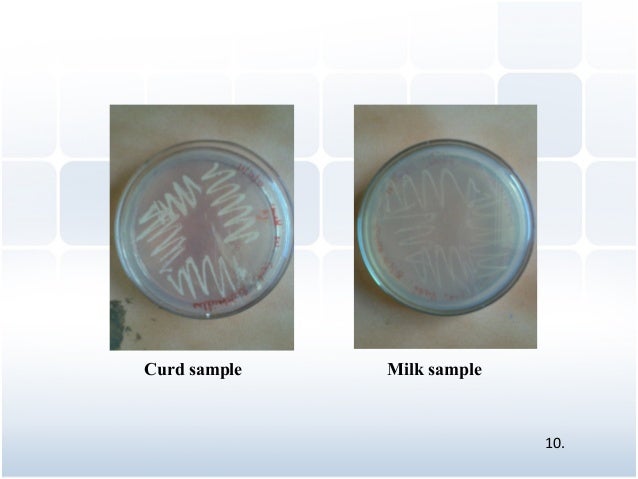
Isolation , characterization and comparative study of lactobacillus s…

If you are looking for Sexton436presentation you've visit to the right page. We have 9 Pics about Sexton436presentation like File:Bacteria - gram-stained vaginal smear 09.jpg - Embryology, Details - Public Health Image Library(PHIL) and also The Lactobacillus Taxonomy change is coming: why, and how to make the. Here you go:
Sexton436presentation
 www.slideshare.net
www.slideshare.net gardnerella vaginalis morphology lactobacillus
Strong Homology Between SARS-CoV-2 Envelope Protein And A Mycobacterium
 europepmc.org
europepmc.org Leuconostoc Mesenteroides / Gram Stain
The Lactobacillus Taxonomy Change Is Coming: Why, And How To Make The
 www.microbiometimes.com
www.microbiometimes.com change why lactobacillus taxonomy coming most lactobacilli classification grounds which
Isolation , Characterization And Comparative Study Of Lactobacillus S…
www.slideshare.net
www.slideshare.net lactobacillus
Details - Public Health Image Library(PHIL)
 phil.cdc.gov
phil.cdc.gov phil cells bacteria human cdc lactobacillus gram vaginal 1048 cytolysis bodies stained pathology outlines gov
Biochemical Reaction - Prac. Microbiology
 www.slideshare.net
www.slideshare.net Blue Light Kills Propionibacterium Acnes (p. Acnes) - LTO
 lighttherapyoptions.com
lighttherapyoptions.com propionibacterium acnes bacteria kills
File:Bacteria - Gram-stained Vaginal Smear 09.jpg - Embryology
 embryology.med.unsw.edu.au
embryology.med.unsw.edu.au vaginal smear lactobacillus vagina mobiluncus bacilli embryology mulieris crispatus acidophilus unsw gola curtisii streptococco
Propionibacterium acnes bacteria kills. Isolation , characterization and comparative study of lactobacillus s…. Sexton436presentation